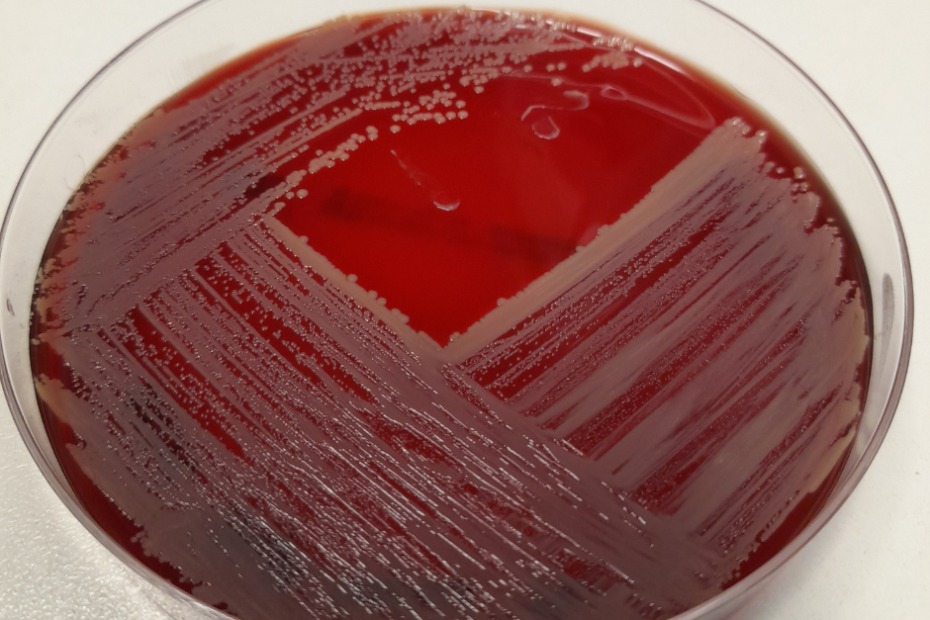

Desinfektion & Sterilisation
auf den Spuren von Semmelweis und Lister

auf den Spuren von Semmelweis und Lister

– die 1000fache Vergrößerung
Staphylococcus aureus

#factmonday – Humanes Bocavirus

#factmonday – EHEC

Keimbelastung reduzieren | Infektionsgefahr senken

#factmonday – Listerien

– über Händehygiene

#factmonday – Parainfluenzavirus

zum ehestmöglichen Zeitpunkt eine Büroassistenz.